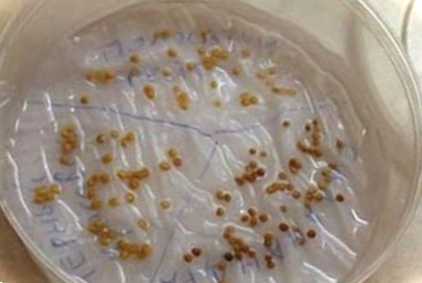

Янтарна кислота для рослин - показання та інструкція щодо застосування на городі

Те, про що сьогодні піде розмова, побічно стосуватиметься майбутнього врожаю. Городникам навіть узимку ніколи розслаблятися, адже в січні вже треба замислюватися про підготовку ґрунту для розсади та купівлю насіння. Важливо заздалегідь потурбуватися про добрива та стимулятори росту, які допоможуть виростити міцну та здорову розсаду. Одним із стимуляторів росту є янтарна кислота, якій зазвичай віддають перевагу Епін, Циркон та інші подібні засоби.

Можливо, хтось уперше чує про неї вперше, а хтось уже застосовував її у городніх справах. Тим часом вона відноситься до натуральних стимуляторів росту і має широкий спектр застосування в медицині, косметології та агрономії. Вона абсолютно нешкідлива і має масу корисних властивостей. Навіть перевищення концентрації вище рекомендованої норми не завдасть жодної шкоди ні людині, ні рослинам.
Зовнішньо - це кристалічний порошок білого кольору, за смаком нагадує лимонну кислоту. Вона міститься в невеликих кількостях у багатьох рослинах, бурштині. У чистому вигляді її можна зустріти в устрицях, кефірі, кисляку, сирі, винах з великим терміном витримки, тобто в продуктах, що проходили процес бродіння. А також вона є в продуктах із вмістом дріжджів, наприклад, у хлібі. Є в ріпі, алое, глід, цукровій тростині, недозрілих ягодах.
Янтарна кислота для рослин - застосування на городі
Відразу слід зазначити, це не добриво. Бурштинова кислота є важливим компонентом обміну речовин у будь-якому живому організмі: у людини, тварин, рослині. Це універсальне джерело енергії. У цьому вона виконує дуже важливу функцію - поповнення енергетичного дефіциту.
Янтарна кислота виробляється всіма організмами, що дихають повітрям. Вона діє одночасно на всі ланки рослини, пробуджуючи апетит. Препарат повністю природного походження.
У чому полягає її дія?
- Активація та прискорення процесів метаболізму, що заповнює енергетичний дефіцит, покращується приживаність;
- Є стресовим адаптогеном, завдяки чому рослини легше адаптуються за несприятливих умов довкілля (посуха, спека, поворотні весняні заморозки, висока вологість);
- Сприяє швидкому відновленню та відростанню кореневої системи після пересадки, рослина швидше приживається на новому місці;
- Завдяки здоровій кореневій системі покращується засвоєння з ґрунту необхідних поживних речовин;
- Найшвидше відростають нові молоді пагони;
- Нормалізує та відновлює корисну мікрофлору в ґрунті;
- Прискорюється цвітіння, дозрівання плодів, їх якість та кількість;
- Підвищується імунітет до захворювань та шкідників, швидше відновлюються хворі та пошкоджені шкідниками;
- Знижується накопичення у тканинах вміст нітратів та інших токсичних речовин.
Наукових обґрунтувань її ефективності досить багато. Через це існують стандартні препарати для використання бурштинової кислоти у садівництві та городництві, головне, щоб вона була присутня у складі.

Показання для застосування янтарної кислоти для рослин
Зважаючи на те, що засіб нетоксичний і нешкідливий, його можна застосовувати для всіх видів рослин: томатів, перців, баклажанів, огірків, капусти, картоплі тощо. д., а також для плодових дерев, чагарників, для кімнатних квітів та для розсади.
Коли можна застосовувати бурштинову кислоту на городі та в саду для рослин?
- Щоб прискорити проростання насіння;
- Коли на етапі вирощування розсади воно кволе, хворе з блідими листочками;
- реанімує пригнічені;
- Після пересадки розсади на постійне місце в теплиці та у відкритому ґрунті, покращується її приживання;
- Підсилює стійкість до поворотних заморозків, у спекотну та посушливу погоду, під час тривалих дощів, коли довго не бачить сонця;
- Щоб підвищити імунітет, адже здорова та міцна рослина легше впорається з хворобами і на неї не нападуть шкідники;
- Прискорює цвітіння та плодоношення.
Застосування бурштинової кислоти щодо тих чи інших частин рослини відповідно стимулює їх зростання. Якщо поливаємо під корінь, значить стимулюється ріст кореневої системи, обприскуємо саму рослину, значить стимулюється ріст молодих пагонів, збільшується цвітіння. Замочуючи насіння перед посівом, покращується їх проростання. А якщо замочити в розчині живці, вони краще потім укореняться на постійному місці. Тому зараз, коли починається розсадний сезон, є сенс звернути увагу на цей препарат.
Як розводити бурштинову кислоту для поливу рослин на городі
Не важливо, ви купили бурштинову кислоту в порошку або таблетках, перед застосуванням необхідно приготувати спочатку водний розчин. Таблетку необхідно розтерти до порошкоподібного стану, розім'явши між двома ложками.
Як правильно приготувати водний розчин? Спочатку необхідно приготувати маточний 1% розчин. Для цього 1 г порошку необхідно спочатку розчинити у невеликій кількості теплої води, так він краще розчиниться. А потім цей розчин довести до об'єму 1 літр. Так чинять, якщо використовують чистий порошок, в якому немає сторонніх домішок.
При розчиненні таблеток зверніть увагу на вагу таблеток та вміст у ній бурштинової кислоти. Так, у таблетці по 0,5 г міститься 0,1 або 0,05 г потрібного засобу, а решта – це допоміжні речовини. Отже, для отримання 1 літра 1% водного розчину необхідно взяти 10 або 20 таблеток відповідно.Приготувавши маточний розчин, вже з нього легко приготувати робочий розчин. Зазвичай для обприскування та поливу застосовують 0,01%, 0,02%, 0,001% та 0,004% розчин.
- Щоб отримати 0,01% робочий розчин, потрібно в 10 л води розчинити 100 мл маткового 1% розчину;
- Для 0,02% розчину 10 л води додаємо 200 мл 1% розчину;
- Відповідно для 0,0001% 10 л води додаємо 100 мл 1% розчину;
- 0,004% розчин готується так: 40 мл 1% вихідного розчину розчиняють у 1 л води.
Приготовлений розчин слід використовувати протягом 3-5 днів, інакше він втратить свої корисні властивості. Особливих заходів безпеки при роботі з ним не потрібно, оскільки речовина не токсична. Засіб швидко розкладається і не накопичується в ґрунті, не забруднює навколишнє середовище.
Важливо зауважити, що янтарна кислота закисляє грунт. Це слід врахувати, оскільки багато овочевих і плодових культур не люблять кислого грунту.Щоб унеможливити таку проблему, потрібно приготований розчин нейтралізувати лугом, а саме додати на 1 л розчину 1 ст. л. аміаку (нашатирного спирту). В цьому випадку утворюється амонійна сіль бурштинової кислоти, інакше сукцинат амонію, тому що в перекладі з латинського слово "succinum" означає бурштин. А ще це буде додаткове джерело азоту.
Інструкція із застосування бурштинової кислоти на городі
Застосування бурштинової кислоти дуже широке у садівництві та городництві. Насамперед її застосування завжди має бути обґрунтованим. Розчини засобу варто застосовувати лише тоді, коли жодні інші заходи не дозволяють добре розвиватися розсаді або рослині в цілому. Хорошим стимулюючим ефектом має родючий грунт, органічні речовини тією чи іншою мірою містять також стимулюючі речовини.
Замочування насіння перед посівом
Для замочування насіння застосовується 0,004% розчин. Для цього 40 мл 1% розчину виливають у банку доводять об'єм до 1 л. Насіння замочують безпосередньо в розчині, або в тканині, змоченій цим же розчином, витримують не більше доби, потім насіння просушують і готові вони для посіву.
Витримане насіння сходить швидко і дружно, сіянці виходять міцними, добре розвиваються, практичні не хворіють.
Обприскування рослин
Для обприскування листя ранньою весною з метою підвищення стійкості до поворотних весняних заморозків застосовують 0,01% розчин. А міцнішим 0,02% розчином – обприскують ще 2 рази, але тільки до цвітіння і вже після того, як рослини відцвітуть. Ці обприскування спрямовані на підвищення імунітету та підвищення стійкості переносити несприятливі умови та можливі захворювання.
Обприскувати можна будь-які овочеві культури, плодові дерева, чагарники, виноградну лозу та садові квіти.
Стимулювання зростання черешків
При живцювання та кращого укорінення живці замочують у 0,01-0,02% розчині на 10-15 годин, потім висаджують у ґрунт на постійне місце. Такі живці швидко утворюють нові коріння і добре приживаються.

Для прискорення проростання
Щоб картопля після посадки швидше проросла для цього застосовують 0,04% розчин янтарної кислоти. Для цього обприскуйте бульби картоплі та витримайте під плівкою до повного висихання розчину на поверхні бульб.
При пересадженні рослин
Пересаджуючи саджанці плодових дерев і чагарники, а також квіти помістіть їх коріння в 0,02% янтарної кислоти на кілька годин, а потім висаджуйте в ямку на постійне місце. Це дозволить прискорити період загоєння ран на корінні, а рослина краще приживеться на новому місці.

Застосування бурштинової кислоти для поливу огірків
Однією з найулюбленіших культур на ділянці є огірки. До їх вирощування городники ставляться з особливою турботою, оскільки це теплолюбна культура, що швидко уражається хворобами і погано переносить будь-які стреси. Бурштинова кислота допоможе згладити всі ці неприємні фактори.
Перед посадкою насіння огірків у ґрунт замочіть насіння в 0,01% розчині на добу, потім просушіть і насіння буде готове для посіву в ґрунт. Якщо ви висаджуєте огірки розсадою, то після висадки полийте ґрунт таким самим розчином. Тим самим простимулюється зростання коренів і швидше сформуються нові коріння. Завдяки добре розвиненій кореневій системі, рослина отримуватиме повною мірою всі поживні речовини з ґрунту, швидше зміцніє і плодоноситиме.
Обприскуючи дорослу рослину за листям 0,01-0,02%, ви стимулюєте утворення нових пагонів і зав'язей, а також підвищите стійкість до хвороб та шкідників. Провівши повторну обробку через 2-3 тижні, ви помітите швидше дозрівання плодів та тривале плодоношення. Для обприскування готують розчин у теплій воді з температурою не менше ніж 18ºС.

Полив помідорів розчином янтарної кислоти
Помідори дуже добре відгукуються застосування цього засобу.
- Бурштинова кислота допомагає боротися з перепадами навколишньої температури та дефіцитом вологи.
- Оброблене насіння та рослини самостійно протистоять шкідникам, а також вірусам та грибкам.
- Сприяє утворенню нових зав'язей, більш дружному цвітінню та зав'язуванню плодів, а самі плоди стають більш солодкими та смачними, у них більше утворюється корисних речовин.
- Під кущами помідорів формується корисна мікрофлора, яка також позитивно впливає.
Для замочування насіння до 2 г (неповна чайна ложка) порошку бурштинової кислоти розводять у невеликій кількості теплої води, розмішують, а потім об'єм води доводять до 1 літра. Посівний матеріал витримують добу в розчині, потім висушують і висівають у ґрунт на розсаду.
Сіянці та дорослі рослини поливають або обприскують розчином, приготованим з розрахунку 2 г порошку на 20 л води (2 відра), помідори поливають під корінь з лійки без розсіювача тонким цівком. На один корінь використовують 0,5-1 л розчину. Таким розчином можна поливати дорослі томати, що ростуть у теплиці та у відкритому ґрунті.

Дорослі рослини краще поливати в період активної появи бутонів 3 рази за сезон з інтервалом 2 тижні. Тим самим ви значно збільшите врожайність помідорів з кожного куща.
Як застосовувати янтарну кислоту для кімнатних квітів
Засіб можна успішно застосовувати для кімнатних квітів. Це дозволить їм ожити буквально вже за тиждень.
Зробіть водний розчин бурштинової кислоти з розрахунку 1 г порошку 5 л теплої води, розмішайте і полийте квіти під корінець. Результати ви вже помітите за тиждень і будете більше, ніж здивовані. Біля кімнатних квітів. зазеленіє листя, з'являться нові бутони на квітучих рослинах.
Однак, не забувайте, що це не підживлення, а лише стимулятор і тому не варто його використовувати часто. Достатньо 1 разу на півроку.
Відгуки про застосування янтарної кислоти для орхідей
Для когось виростити орхідеї досить складне завдання. Купивши в магазині квітучу орхідею, вона часом швидко відцвітає, а потім від неї довго не можуть дочекатися квітконосів. У інших вона цвіте довго і випускає до 10-12 суцвіть. У чому причина, чому в одних орхідеї цвітуть, а в буквальному розумінні, чахнуть. Як простимулювати рослину, щоб вона радувала нас своїм цвітінням? І тут на допомогу приходить янтарна кислота.
Вона позитивно впливає на всю рослину в цілому. Якщо квітка зупинилася в рості, не випускає коріння, полийте її водним розчином засобу і протріть листя. Орхідея швидко відгукнеться на турботу, у неї почнуть відростати нове коріння, і квітка почне викидати міцні квітконоси. Та й самі квіти будуть великими, міцними і довше цвітимуть. Крім того, знешкоджуватимуть шкідливі речовини в ґрунті, які можуть згубно позначитися на розвитку орхідеї.

Для стимуляції розведіть 1 таблетку бурштинової кислоти (або порошку на кінчику ножа) у 1 л теплої води, розмішайте. Перелийте розчин в пульверизатор і обприскайте нижнє листя і кореневу шийку, а розчин, що залишився, вилийте в невелику миску і поставте туди горщик з орхідеєю. Рослина вбере в себе розчину, скільки потрібно. Дайте стекти зайвої рідини. Розчином, що залишився, протріть листя.
Але знайте, що різні види орхідей потребують різної концентрації розчину. Спостерігайте за реакцією квітки, хоча навіть великі дози йому не зашкодять, але маленькі дози не позитивно впливають.
А ось які відгуки про застосування янтарної кислоти для орхідей я знайшла в інтернеті.
AnnA1988, Москва
Бурштинову кислоту вирішила використати я не за прямим призначенням, вичитала в інтернеті, що їй можна підгодувати орхідею. Справа в тому, що дві орхідеї, що живуть на підвіконні на кухні, вже більше року стояли і не цвіли, не росло нове листя і коріння. Вони ніби завмерли.
Тоді вирішила використати янтарну кислоту, 1 таблетку розвела десь у літрі теплої води, і замочила в цьому розчині мої розтюхи на півгодини, цим же розчином протерла листя. Зробила я так кілька разів, не особливо сподіваючись на результат. У результаті я була здивована, коли одна орхідея випустила квітконос. а друга дала новий лист і нове коріння!
Marinazar, Щвеція
У черговий сплеск інтересу детально почала читати форуми любителів орхідей і неодноразово натикалася на рекомендації застосування янтарної кислоти. Але фото і відео показували буквально за пару тижнів воскреслі рослини з бажанням цвісти. Я купила упаковок бурштинової кислоти, благо коштує вона всього 9 рублів за блістер. Строго слідувала порадам з форумів: розводила по пігулці на літр води, замочувала у ванній горщики з орхідеями, давала воді стекти. В решту часу завзято обприскувала листя та коріння. Отримували цю воду та інші рослини (ну а чого добре пропадати?).
Визначила контрольну групу з 2 орхідей, яких фотографувала після кожного поливу. За 6 тижнів застосування, на жаль, не побачила жодного результату. Чи то я щось не так роблю, чи метод не працює, чи орхідеї страйкують.
Від себе скажу, що доки не спробуєш на собі якісь рекомендації, важко оцінити гідність чи шкоду якогось засобу. Застосовуючи бурштинову кислоту як стимулятора росту для своїх рослин, пам'ятайте, що вона закисляє грунт. І тому безконтрольне її застосування може навіть зашкодити. І хоча передозування засобом не буває, все-таки часті обробки не рекомендуються, все добре в міру.
Успіхів вам!

